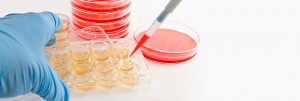

Ultime notizie
Lettera di una paziente che con delicatezza e sensibilità racconta la sua miopia24 Marzo 2025 - 11:48
Articolo su “Il Mattino” edizione Salerno del 7 Febbraio 2025 – Acquavella, la storia del dottor Garzione7 Febbraio 2025 - 18:29
UNA NUOVA ESPERIENZA AL SUD CON UN PROGETTO: CONIUGARE ALTA TECNOLOGIA E SOSTENIBILITÀ28 Ottobre 2024 - 10:40
MEDICINA DELL’INCLUSIONE IN OFTALMOLOGIA24 Ottobre 2024 - 09:27
INTERVENTO PER ESITI DI PARALISI DEL FACCIALE CON TARSORRAFIA LATERALE E FILI DI SOSPENSIONE PERMANENTI24 Settembre 2024 - 12:09
Seguici su Facebook
Tag
anelli intrastrominali anestesia angio oct atrofia del nervo ottico avastin cataratta Cheratocono chirurgia delle vie lacrimali chirurgia refrattiva chirurgia vitreo retinica corsoecm Dacriocistorinostomia degenerazione maculare senile edema maculare Endoscopia nasale epiretiniche Femtolaser foro maculare intervento di cataratta ipermetropia laser ad eccimeri laser a diodi Laser a femtosecondi laser argon laser yag macula malattie retiniche miopia OCT oftalmopatia tiroidea PRK ptosi palpebrale pucker pucker maculare puker maculare retina retinopatia diabetica retrazione palpebrale simposio oculistico sindrome interfaccia vitreo retinica trattamenti anti-aging trombosi venosa retinica vie lacrimali vitrectomia vitreopatia
Sede di Roma – Via Carlo Poma, 2
Struttura sanitaria con vigilanza e videosorveglianza h24

Lascia un Commento
Vuoi partecipare alla discussione?Fornisci il tuo contributo!